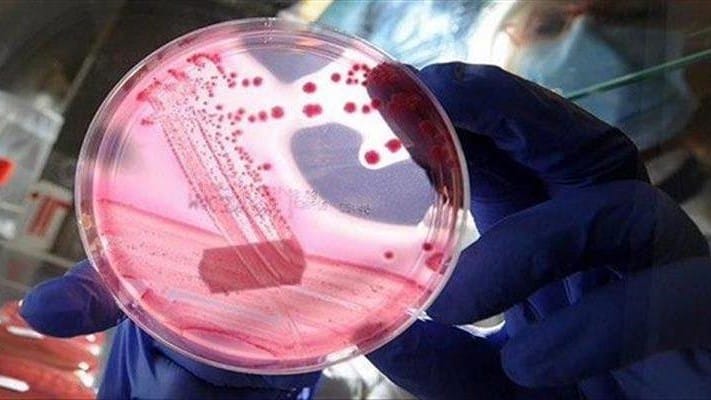
تووشبووێکی دیکە بە تای خوێنبەربوون لە زاخۆ تۆمار کرا

پشکنینی تای خوێنبەربوون
ئاڤا نیوز
پیاوێکی تەمەن 28 ساڵ کە خەڵکی بیکۆڤایە لە قەزای باتیفا، تووشی نەخۆشی تای خوێنبەربوون بووە و ئێستا لە ژێرد چاودێریی پزیشکیدایە.
وێنە گەورەکە: دوای بوونی چەندین گومانلێکراو بە نەخۆشی تای خوێنبەربوون لە هەرێمی کوردستان، لەماوەی دوو مانگی ڕابردوو تەنیا پێنج تووشبوو دەسنیشانکراون و پشتڕاستکراوەنەتەوە، یەکێک لە تووشبووانیش گیانی لەدەستداوە.
ڕاگەیێنراوی فەرمی: وەزارەتی تەندروستی حکومەتی هەرێمی کوردستان ڕایگەیاند، ئەو کەسەی تووشی نەخۆشی تای خوێنبەربوون بووە پیشەی ئاژەڵدارە و بەرکەوتەی ئاژەڵی تووشبوو بووە، دوای گومانلێکردن بە نەخۆشی تای خوێنبەربوون و بوونی نیشانەکانی و چەندین ڕێکاری دەستنیشانکردن و چارەسەری پزیشکی گیراوەتەبەر، ئێستا لەژێر چاودێریی پزیشکی لە نەخۆشخانە خەوێندراوە و چارەسەر وەردەگرێت و تا ئێستا باری تەندروستی جێگیرە.
وەزارەتی تەندروستی، "داوا لە هاووڵاتیان دەکەین و جەخت دەکەینەوە لەسەر جێبەجێکردنی ڕێنماییەکانی وەزارەتی تەندروستی، لەکاتی بوونی گومان و نیشانەکانی نەخۆشی لەسەر ئاژەڵ پێویستە تیمەکانی ڤێتەرنەری ئاگاداربکەنەوە"، هاوکات بەرکەوتووانی بەخێوکردنی ئاژەڵ یان بەرهەمەکانی ئاژەڵ لەکاتی بوونی هەر نیشانەیەکی ناتەندروست، بەخێرایی سەردانی نەخۆشخانەکان بکەن بێ دواکەوتن.
ئەوەی پێویستە بیزانیت: سەجەم ئەو کەسانەی لە هەرێمی کوردستان تووشی نەخۆشی تای خوێنبەربوون بوون، تەنیا یەکێکیان لەبەر قورسی باری تەندروستی گیانی لەدەستدا و ئەوانەی دیکە بەتەواوی چاکبوونەتەوە و لە نەخۆشخانە دەرچوونە.
زیاتر لەسەر ئەم بابەتانە بکۆڵەرەوە
دوایین هەواڵەکان
- هەواڵ
- 5 کاتژمێر لەمەوپێش
ئیمارات بۆ ڕووبەڕووبوونەوەی گەرما فێنککەرەوە لە گۆڕستانەکان دادەنێت
- کوردستان
- 5 کاتژمێر لەمەوپێش
كارەكانی سایلۆی هەڵەبجە 85%ـی تەواو بووە
- کوردستان
- 5 کاتژمێر لەمەوپێش
فایلی خەڵک؛ کارکردن لە پڕۆژەی دوو سایدی گەڕەکی ژین دەستی پێکردەوە
هەڵبژاردەکان بۆ تۆ
ئیمارات بۆ ڕووبەڕووبوونەوەی گەرما فێنککەرەوە لە گۆڕستانەکان دادەنێت
5 کاتژمێر لەمەوپێش
پەرەسەندنی تەکنەلۆژیا لە چین؛ سواڵکردنیش بووە بە ئەلیکترۆنی
5 کاتژمێر لەمەوپێش
ئەو کەسەی لە هەولێر فێڵی لە خێزانێکی ڕۆژهەڵاتی کوردستان کرد دەستگیر کرا
5 کاتژمێر لەمەوپێش
هەڵەیەکی پزیشکی لە هەولێر 10 ساڵ ژیانی کچێک تێکدەدات
5 کاتژمێر لەمەوپێش
باوکێک بە تەنیا کوڕە تووشبووەکەی بە ئۆتیزم بەخێو دەکات و دەستبەرداری ژیانی خۆی بووە
5 کاتژمێر لەمەوپێش
- تەندروستی
- 5 کاتژمێر لەمەوپێش
ئەو کەسەی لە هەولێر فێڵی لە خێزانێکی ڕۆژهەڵاتی کوردستان کرد دەستگیر کرا
- تەندروستی
- 5 کاتژمێر لەمەوپێش
هەڵەیەکی پزیشکی لە هەولێر 10 ساڵ ژیانی کچێک تێکدەدات
- تەندروستی
- 19 کاتژمێر لەمەوپێش
بۆ یەکەمجارە سەنتەری دڵنیایی پشکنینی تاقیگەیی لە هەولێر دەکرێتەوە